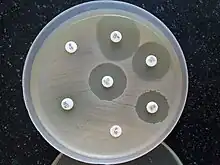

Clindamycin
 | |
 | |
| Names | |
|---|---|
| Pronunciation | /klɪndəˈmaɪsɪn/ |
| Trade names | Cleocin, Clinacin, Dalacin, others |
| Other names | 7-chloro-lincomycin 7-chloro-7-deoxylincomycin |
IUPAC name
| |
| Clinical data | |
| Drug class | Lincosamide antibiotic[1] |
| Main uses | Bacterial infections (bone or joint infections, pelvic inflammatory disease, strep throat, pneumonia, middle ear, endocarditis)[2] |
| Side effects | Nausea, diarrhea, rash, pain at the site of injection[2] |
| Pregnancy category | |
| Routes of use | By mouth, topical, IV, intravaginal |
| Defined daily dose | 1,200 mg (by mouth)[4] 1,800 mg (by injection)[4] |
| External links | |
| AHFS/Drugs.com | Systemic: Monograph Topical: Monograph |
| MedlinePlus | a682399 |
| Legal | |
| License data |
|
| Legal status | |
| Pharmacokinetics | |
| Bioavailability | 90% (by mouth) 4–5% (topical) |
| Protein binding | 95% |
| Metabolism | Liver |
| Elimination half-life | 2–3 hours |
| Excretion | Biliary and kidney (around 20%) |
| Chemical and physical data | |
| Formula | C18H33ClN2O5S |
| Molar mass | 424.98 g·mol−1 |
| 3D model (JSmol) | |
SMILES
| |
InChI
| |
Clindamycin is an antibiotic used for the treatment of a number of bacterial infections, including bone or joint infections, pelvic inflammatory disease, strep throat, pneumonia, middle ear infections, and endocarditis.[2] It can also be used to treat acne,[2][5] and some cases of methicillin-resistant Staphylococcus aureus (MRSA).[6] In combination with quinine, it can be used for malaria.[2][5] It is available by mouth, by injection into a vein, and as a cream to be applied to the skin or in the vagina.[2][5]
Common side effects include nausea, diarrhea, rash, and pain at the site of injection.[2] It increases the risk of hospital-acquired Clostridium difficile colitis about fourfold and thus is only recommended when other antibiotics are not appropriate.[7][2] Alternative antibiotics may be recommended as a result.[2] It appears to be generally safe in pregnancy.[2] It is of the lincosamide class and works by blocking bacteria from making protein.[2]
Clindamycin was first made in 1966 from lincomycin.[8][9][10] It is on the World Health Organization's List of Essential Medicines.[11] It is available as a generic medication and is not very expensive.[12] The wholesale cost in the developing world is about US$0.06–0.12 per pill.[13] In the United States, it costs about $2.70 per dose.[2] In 2017, it was the 137th most commonly prescribed medication in the United States, with more than four million prescriptions.[14][15]
Medical uses
Clindamycin is used primarily to treat anaerobic infections caused by susceptible anaerobic bacteria, including dental infections,[16] and infections of the respiratory tract, skin, and soft tissue, and peritonitis.[17] In people with hypersensitivity to penicillins, clindamycin may be used to treat infections caused by susceptible aerobic bacteria, as well. It is also used to treat bone and joint infections, particularly those caused by Staphylococcus aureus.[17][18] Topical application of clindamycin phosphate can be used to treat mild to moderate acne.[19]
Acne
For treatment of acne, in the long term the combined use of topical clindamycin and benzoyl peroxide was similar to salicylic acid plus benzoyl peroxide.[20] Topical clindamycin plus topical benzoyl peroxide is more effective than topical clindamycin alone.[20]
Susceptible bacteria
It is most effective against infections involving the following types of organisms:
- Aerobic Gram-positive cocci, including some members of the Staphylococcus and Streptococcus (e.g. pneumococcus) genera, but not enterococci.[21]
- Anaerobic, Gram-negative rod-shaped bacteria, including some Bacteroides, Fusobacterium, and Prevotella, although resistance is increasing in Bacteroides fragilis.
Most aerobic Gram-negative bacteria (such as Pseudomonas, Legionella, Haemophilus influenzae and Moraxella) are resistant to clindamycin,[21][22] as are the facultative anaerobic Enterobacteriaceae.[23] A notable exception is Capnocytophaga canimorsus, for which clindamycin is a first-line drug of choice.[24]
The following represents MIC susceptibility data for a few medically significant pathogens.[25]
- Staphylococcus aureus: 0.016 μg/ml - >256 μg/ml
- Streptococcus pneumoniae: 0.002 μg/ml - >256 μg/ml
- Streptococcus pyogenes: <0.015 μg/ml - >64 μg/ml
D-test
When testing a gram-positive culture for sensitivity to clindamycin, it is common to perform a "D-test" to determine if there is a macrolide-resistant subpopulation of bacteria present. This test is necessary because some bacteria express a phenotype known as MLSB, in which susceptibility tests will indicate the bacteria are susceptible to clindamycin, but in vitro the pathogen displays inducible resistance.
To perform a D-test, an agar plate is inoculated with the bacteria in question and two drug-impregnated disks (one with erythromycin, one with clindamycin) are placed 15–20 mm apart on the plate. If the area of inhibition around the clindamycin disk is "D" shaped, the test result is positive and clindamycin should not be used due to the possibility of resistant pathogens and therapy failure. If the area of inhibition around the clindamycin disk is circular, the test result is negative and clindamycin can be used.[26]
Malaria
Given with chloroquine or quinine, clindamycin is effective and well tolerated in treating Plasmodium falciparum malaria; the latter combination is particularly useful for children, and is the treatment of choice for pregnant women who become infected in areas where resistance to chloroquine is common.[27][28] Clindamycin should not be used as an antimalarial by itself, although it appears to be very effective as such, because of its slow action.[27][28] Patient-derived isolates of Plasmodium falciparum from the Peruvian Amazon have been reported to be resistant to clindamycin as evidenced by in vitro drug susceptibility testing.[29]
Other

Clindamycin may be useful in skin and soft tissue infections caused by methicillin-resistant Staphylococcus aureus (MRSA).[6] Many strains of MRSA are still susceptible to clindamycin; however, in the United States spreading from the West Coast eastwards, MRSA is becoming increasingly resistant.
While it has been used in intraabdominal infections, such use is generally not recommended due to resistance.[2]
Clindamycin is used in cases of suspected toxic shock syndrome,[30] often in combination with a bactericidal agent such as vancomycin. The rationale for this approach is a presumed synergy between vancomycin, which causes the death of the bacteria by breakdown of the cell wall, and clindamycin, which is a powerful inhibitor of toxin synthesis. Both in vitro and in vivo studies have shown clindamycin reduces the production of exotoxins by staphylococci;[31] it may also induce changes in the surface structure of bacteria that make them more sensitive to immune system attack (opsonization and phagocytosis).[32][33]
Clindamycin has been proven to decrease the risk of premature births in women diagnosed with bacterial vaginosis during early pregnancy to about a third of the risk of untreated women.[34]
The combination of clindamycin and quinine is the standard treatment for severe babesiosis.[35]
Clindamycin may also be used to treat toxoplasmosis,[21][36][37] and, in combination with primaquine, is effective in treating mild to moderate Pneumocystis jirovecii pneumonia.[38]
Clindamycin, either applied to skin or taken by mouth, may also be used in hidradenitis suppurativa.[39]
Dosage
It is generally used as 150 to 450 mg by mouth three to four times a day in adults.[40] The intravenous formulation is generally given at 600 to 900 mg three times per day.[40] Treatment duration is typically 7 to 14 days.[40]
In children the dose is 10 to 40 mg/kg per day divided into three or four doses.[40] In those less than 2 kg and in the first 7 days of life the dose is 5 mg/kg every 12 hours by injection, otherwise in those more than 2 kg or 2nd to 4th week of life the dose is 5 mg/kg every 8 hours intravenously.[1] It is recommended to change to the medication by mouth as soon as possible.[1]
The defined daily dose is 1,200 mg by mouth and 1,800 mg by injection.[41][4]
Side effects
Common side effects associated with systemic clindamycin therapy – found in over 1% of people – include: diarrhea, pseudomembranous colitis, nausea, vomiting, abdominal pain or cramps and/or rash. High doses (both intravenous and oral) may cause a metallic taste. Common adverse drug reactions associated with topical formulations – found in over 10% of people – include: dryness, burning, itching, scaliness, or peeling of skin (lotion, solution); erythema (foam, lotion, solution); oiliness (gel, lotion). Additional side effects include contact dermatitis.[42][43] Common side effects – found in over 10% of people – in vaginal applications include fungal infection.
Rarely – in less than 0.1% of people – clindamycin therapy has been associated with anaphylaxis, blood dyscrasias, polyarthritis, jaundice, raised liver enzyme levels, kidney problems, cardiac arrest, or liver toxicity.[42]
Clostridium difficile
Pseudomembranous colitis is a potentially lethal condition commonly associated with clindamycin, but which also occurs with other antibiotics.[7][44] Overgrowth of Clostridium difficile, which is inherently resistant to clindamycin, results in the production of a toxin that causes a range of adverse effects, from diarrhea to colitis and toxic megacolon.[42][45]
Pregnancy and breastfeeding
Use of clindamycin during pregnancy is generally considered safe.[46]
Clindamycin is classified as compatible with breastfeeding by the American Academy of Pediatrics,[47] however, the WHO categorizes it as "avoid if possible".[48] It is classified as L2 probably compatible with breastfeeding according to Medications and Mothers' Milk.[49] A 2009 review found it was likely safe in breastfeeding mothers, but did find one complication (hematochezia) in a breastfed infant which might be attributable to clindamycin.[50] LactMed lists potentially negative gastrointestinal effects in babies whose mothers take it while breastfeeding but did not see that as justification to stop breastfeeding.[51]
Interactions
Clindamycin may prolong the effects of neuromuscular-blocking drugs, such as succinylcholine and vecuronium.[52][53][54] Its similarity to the mechanism of action of macrolides and chloramphenicol means they should not be given simultaneously, as this causes antagonism[22] and possible cross-resistance.
Mechanism of action

Clindamycin has a primarily bacteriostatic effect. At higher concentrations, it may be bactericidal.[55] It is a bacterial protein synthesis inhibitor by inhibiting ribosomal translocation,[56] in a similar way to macrolides. It does so by binding to the 50S rRNA of the large bacterial ribosome subunit, overlapping with the binding sites of the oxazolidinone, pleuromutilin, and macrolide antibiotics, among others.[21][57] The binding is reversible.[58] Clindamycin is more effective than lincomycin.[55]
The X-ray crystal structures of clindamycin bound to ribosomes (or ribosomal subunits) derived from Escherichia coli,[59] Deinococcus radiodurans,[60] and Haloarcura marismortui[61] have been determined; the structure of the closely related antibiotic lincomycin bound to the 50S ribosomal subunit of Staphylococcus aureus has also been reported.[62]
Chemistry

Clindamycin is a semisynthetic derivative of lincomycin, a natural antibiotic produced by the actinobacterium Streptomyces lincolnensis. It is obtained by 7(S)-chloro-substitution of the 7(R)-hydroxyl group of lincomycin.[64][65] The synthesis of clindamycin was first announced by BJ Magerlein, RD Birkenmeyer, and F Kagan on the fifth Interscience Conference on Antimicrobial Agents and Chemotherapy (ICAAC) in 1966.[66] It has been on the market since 1968.[43]
Clindamycin is white or yellow.[55] It is very soluble in water.[55] The topically used clindamycin phosphate is a phosphate-ester prodrug of clindamycin.[63]
Society and culture
Cost
Clindamycin is available as a generic medication and is not very expensive.[12][67] The wholesale cost in the developing world is about US$0.06 to US$0.12 per pill.[68] In the United States it costs about $2.70 per dose.[2]
-
.svg.png) Clindamycin costs (USA)
Clindamycin costs (USA) -
.svg.png) Clindamycin prescriptions (USA)
Clindamycin prescriptions (USA)
Available forms

Clindamycin preparations that are taken by mouth include capsules (containing clindamycin hydrochloride) and oral suspensions (containing clindamycin palmitate hydrochloride).[27] Oral suspension is not favored for administration of clindamycin to children, due to its extremely foul taste and odor. Clindamycin is formulated in a vaginal cream and as vaginal ovules for treatment of bacterial vaginosis.[34] It is also available for topical administration in gel form, as a lotion, and in a foam delivery system (each containing clindamycin phosphate) and a solution in ethanol (containing clindamycin hydrochloride) and is used primarily as a prescription acne treatment.[69]
Several combination acne treatments containing clindamycin are also marketed, such as single-product formulations of clindamycin with benzoyl peroxide—sold as BenzaClin (Sanofi-Aventis), Duac (a gel form made by Stiefel), and Acanya, among other trade names—and, in the United States, a combination of clindamycin and tretinoin, sold as Ziana.[70] In India, vaginal suppositories containing clindamycin in combination with clotrimazole are manufactured by Olive Health Care and sold as Clinsup-V. In Egypt, vaginal cream containing clindamycin produced by Biopharmgroup sold as Vagiclind indicated for vaginosis.
Clindamycin is available as a generic drug, for both systemic (oral and intravenous) and topical use.[27] (The exception is the vaginal suppository, which is not available as a generic in the USA[71]).
Clindamycin is marketed as generic and under trade names including Cleocin HCl, Clindacin, Dalacin, Evoclin and Lincocin (Bangladesh). Other combination products include Clindoxyl.
Veterinary use
The veterinary uses of clindamycin are quite similar to its human indications, and include treatment of osteomyelitis,[72] skin infections, and toxoplasmosis, for which it is the preferred drug in dogs and cats.[73] They can be used both by mouth and topically.[55] A disadvantage is that bacterial resistance can develop fairly quickly.[55] Gastrointestinal upset may also occur.[55] Toxoplasmosis rarely causes symptoms in cats, but can do so in very young or immunocompromised kittens and cats.
References
- ↑ 1.0 1.1 1.2 "CLINDAMYCIN injectable - Essential drugs". medicalguidelines.msf.org. Archived from the original on 28 August 2021. Retrieved 1 September 2020.
- ↑ 2.00 2.01 2.02 2.03 2.04 2.05 2.06 2.07 2.08 2.09 2.10 2.11 2.12 2.13 "Clindamycin Hydrochloride". The American Society of Health-System Pharmacists. Archived from the original on 5 September 2015. Retrieved 4 September 2015.
- ↑ 3.0 3.1 Use During Pregnancy and Breastfeeding
- ↑ 4.0 4.1 4.2 "WHOCC - ATC/DDD Index". www.whocc.no. Archived from the original on 10 November 2020. Retrieved 30 August 2020.
- ↑ 5.0 5.1 5.2 Leyden, James J. (2006). Hidradenitis suppurativa. Berlin: Springer. p. 152. ISBN 9783540331018. Archived from the original on 8 September 2017. Archived 14 January 2023 at the Wayback Machine "Archive copy". Archived from the original on 14 January 2023. Retrieved 30 August 2017.
{{cite web}}: CS1 maint: archived copy as title (link) CS1 maint: bot: original URL status unknown (link) - ↑ 6.0 6.1 Daum RS (July 2007). "Clinical practice. Skin and soft-tissue infections caused by methicillin-resistant Staphylococcus aureus". N. Engl. J. Med. 357 (4): 380–90. doi:10.1056/NEJMcp070747. PMID 17652653.
- ↑ 7.0 7.1 Thomas C, Stevenson M, Riley TV (2003). "Antibiotics and hospital-acquired Clostridium difficile-associated diarrhoea: a systematic review" (PDF). J Antimicrob Chemother. 51 (6): 1339–50. doi:10.1093/jac/dkg254. PMID 12746372. Archived (PDF) from the original on 7 January 2016.
- ↑ Smieja, Marek (1998). "Current indications for the use of clindamycin: A critical review". The Canadian Journal of Infectious Diseases. 9 (1): 22–28. doi:10.1155/1998/538090. ISSN 1180-2332. PMC 3250868. PMID 22346533.
{{cite journal}}: CS1 maint: unflagged free DOI (link) - ↑ Neonatal Formulary: Drug Use in Pregnancy and the First Year of Life (7 ed.). John Wiley & Sons. 2014. p. 162. ISBN 9781118819517. Archived from the original on 8 September 2017.
- ↑ Smieja, M. (January–February 1998). "Current indications for the use of clindamycin: A critical review". Can J Infect Dis. 9 (1): 22–28. doi:10.1155/1998/538090. PMC 3250868. PMID 22346533.
{{cite journal}}: CS1 maint: unflagged free DOI (link) - ↑ World Health Organization (2019). World Health Organization model list of essential medicines: 21st list 2019. Geneva: World Health Organization. hdl:10665/325771. WHO/MVP/EMP/IAU/2019.06. License: CC BY-NC-SA 3.0 IGO.
- ↑ 12.0 12.1 Hamilton, Richart (2015). Tarascon Pocket Pharmacopoeia 2015 Deluxe Lab-Coat Edition. Jones & Bartlett Learning. p. 108. ISBN 9781284057560.
- ↑ "Clindamycin". International Drug Price Indicator Guide. Archived from the original on 7 January 2016. Retrieved 6 September 2015.
- ↑ "The Top 300 of 2020". ClinCalc. Archived from the original on 12 February 2021. Retrieved 11 April 2020.
- ↑ "Clindamycin - Drug Usage Statistics". ClinCalc. Archived from the original on 8 July 2020. Retrieved 11 April 2020.
- ↑ Brook I, Lewis MA, Sándor GK, Jeffcoat M, Samaranayake LP, Vera Rojas J (November 2005). "Clindamycin in dentistry: more than just effective prophylaxis for endocarditis?". Oral Surg Oral Med Oral Pathol Oral Radiol Endod. 100 (5): 550–8. doi:10.1016/j.tripleo.2005.02.086. PMID 16243239.
- ↑ 17.0 17.1 "Cleocin I.V. Indications & Dosage". RxList.com. 2007. Archived from the original on 27 November 2007. Retrieved 1 December 2007.
- ↑ Darley ES, MacGowan AP (2004). "Antibiotic treatment of gram-positive bone and joint infections" (PDF). J Antimicrob Chemother. 53 (6): 928–35. doi:10.1093/jac/dkh191. PMID 15117932. Archived (PDF) from the original on 6 November 2015.
- ↑ Feldman S, Careccia RE, Barham KL, Hancox J (May 2004). "Diagnosis and treatment of acne" (PDF). Am Fam Physician. 69 (9): 2123–30. PMID 15152959. Archived (PDF) from the original on 27 July 2011.
- ↑ 20.0 20.1 Seidler EM, Kimball AB (July 2010). "Meta-analysis comparing efficacy of benzoyl peroxide, clindamycin, benzoyl peroxide with salicylic acid, and combination benzoyl peroxide/clindamycin in acne". J. Am. Acad. Dermatol. 63 (1): 52–62. doi:10.1016/j.jaad.2009.07.052. PMID 20488582.
- ↑ 21.0 21.1 21.2 21.3 "Lincosamides, Oxazolidinones, and Streptogramins". Merck Manual of Diagnosis and Therapy. Merck & Co. November 2005. Archived from the original on 2 December 2007. Retrieved 1 December 2007.
- ↑ 22.0 22.1 Bell EA (January 2005). "Clindamycin: new look at an old drug". Infectious Diseases in Children. Archived from the original on 8 October 2011. Retrieved 1 December 2007.
- ↑ Gold, Howard S.; Moellering, Jr., Robert C. (1999). "Macrolides and clindamycin". In Root, Richard E.; Francis Waldvogel; Lawrence Corey; Walter E. Stamm (eds.). Clinical infectious diseases: a practical approach. Oxford: Oxford University Press. pp. 291–7. ISBN 978-0-19-508103-9. Archived from the original on 13 May 2018."Archive copy". Archived from the original on 14 January 2023. Retrieved 4 November 2016.
{{cite web}}: CS1 maint: archived copy as title (link)"Archive copy". Archived from the original on 14 January 2023. Retrieved 4 November 2016.{{cite web}}: CS1 maint: archived copy as title (link) CS1 maint: bot: original URL status unknown (link) Retrieved January 19, 2009.through Google Book Search. - ↑ Jolivet-Gougeon A, Sixou JL, Tamanai-Shacoori Z, Bonnaure-Mallet M (April 2007). "Antimicrobial treatment of Capnocytophaga infections". Int J Antimicrob Agents. 29 (4): 367–73. doi:10.1016/j.ijantimicag.2006.10.005. PMID 17250994.
- ↑ "Archive copy" (PDF). Archived (PDF) from the original on 22 December 2019. Retrieved 7 April 2014.
{{cite web}}: CS1 maint: archived copy as title (link) - ↑ Woods, Charles. "Macrolide-Inducible Resistance to Clindamycin and the D-Test" (PDF). Archived (PDF) from the original on 7 January 2016. Retrieved 16 June 2012.
- ↑ 27.0 27.1 27.2 27.3 Lell B, Kremsner PG (2002). "Clindamycin as an Antimalarial Drug: Review of Clinical Trials" (PDF). Antimicrobial Agents and Chemotherapy. 46 (8): 2315–20. doi:10.1128/AAC.46.8.2315-2320.2002. ISSN 0066-4804. PMC 127356. PMID 12121898. Archived (PDF) from the original on 29 September 2011.
- ↑ 28.0 28.1 Griffith KS, Lewis LS, Mali S, Parise ME (2007). "Treatment of malaria in the United States: a systematic review". JAMA. 297 (20): 2264–77. doi:10.1001/jama.297.20.2264. PMID 17519416.
- ↑ Dharia NV, Plouffe D, Bopp SE, González-Páez GE, Lucas C, Salas C, Soberon V, Bursulaya B, Kochel TJ, Bacon DJ, Winzeler EA (2010). "Genome scanning of Amazonian Plasmodium falciparum shows subtelomeric instability and clindamycin-resistant parasites". Genome Research. 20 (11): 1534–44. doi:10.1101/gr.105163.110. PMC 2963817. PMID 20829224.
- ↑ Annane D, Clair B, Salomon J (2004). "Managing toxic shock syndrome with antibiotics". Expert Opin Pharmacother. 5 (8): 1701–10. doi:10.1517/14656566.5.8.1701. PMID 15264985.
- ↑ Coyle EA, Society of Infectious Diseases Pharmacists (2003). "Targeting bacterial virulence: the role of protein synthesis inhibitors in severe infections. Insights from the Society of Infectious Diseases Pharmacists". Pharmacotherapy. 23 (5): 638–42. doi:10.1592/phco.23.5.638.32191. PMID 12741438. Archived from the original on 5 December 2008.
- ↑ Gemmell CG, O'Dowd A (1983). "Regulation of protein A biosynthesis in Staphylococcus aureus by certain antibiotics: its effect on phagocytosis by leukocytes". J Antimicrob Chemother. 12 (6): 587–97. doi:10.1093/jac/12.6.587. PMID 6662837.
- ↑ Gemmell CG, Peterson PK, Schmeling D, et al. (May 1981). "Potentiation of opsonization and phagocytosis of Streptococcus pyogenes following growth in the presence of clindamycin". J Clin Invest. 67 (5): 1249–56. doi:10.1172/JCI110152. PMC 370690. PMID 7014632.
- ↑ 34.0 34.1 Lamont RF (2005). "Can antibiotics prevent preterm birth—the pro and con debate". BJOG. 112 (Suppl 1): 67–73. doi:10.1111/j.1471-0528.2005.00589.x. PMID 15715599.
- ↑ Homer MJ, Aguilar-Delfin I, Telford SR, Krause PJ, Persing DH (July 2000). "Babesiosis" (PDF). Clin Microbiol Rev. 13 (3): 451–69. doi:10.1128/CMR.13.3.451-469.2000. PMC 88943. PMID 10885987. Archived (PDF) from the original on 21 July 2006.
- ↑ Pleyer U, Torun N, Liesenfeld O (2007). "Okuläre Toxoplasmose" [Ocular toxoplasmosis]. Ophthalmologe (in German). 104 (7): 603–16. doi:10.1007/s00347-007-1535-8. PMID 17530262.
{{cite journal}}: CS1 maint: unrecognized language (link) - ↑ Jeddi A, Azaiez A, Bouguila H, et al. (1997). "Intérêt de la clindamycine dans le traitement de la toxoplasmose oculaire" [Value of clindamycin in the treatment of ocular toxoplasmosis]. Journal Français d'Ophtalmologie (in French). 20 (6): 418–22. ISSN 0181-5512. PMID 9296037.
{{cite journal}}: CS1 maint: unrecognized language (link) - ↑ Fishman JA (June 1998). "Treatment of Infection Due to Pneumocystis carinii" (PDF). Antimicrobial Agents and Chemotherapy. 42 (6): 1309–14. doi:10.1128/AAC.42.6.1309. ISSN 0066-4804. PMC 105593. PMID 9624465. Archived (PDF) from the original on 7 January 2016.
- ↑ Saunte, Ditte Marie Lindhardt; Jemec, Gregor Borut Ernst (28 November 2017). "Hidradenitis Suppurativa: Advances in Diagnosis and Treatment". JAMA. 318 (20): 2019–2032. doi:10.1001/jama.2017.16691. ISSN 0098-7484. PMID 29183082. Archived from the original on 28 August 2021. Retrieved 15 March 2022.
- ↑ 40.0 40.1 40.2 40.3 "Clindamycin - WikEM". wikem.org. Archived from the original on 29 September 2020. Retrieved 16 August 2020.
- ↑ "Single Drug Information – International Medical Products Price Guide". Archived from the original on 28 August 2021. Retrieved 16 August 2020.
- ↑ 42.0 42.1 42.2 Rossi S, editor. Australian Medicines Handbook 2006. Adelaide: Australian Medicines Handbook; 2006.
- ↑ 43.0 43.1 De Groot, M. C. H.; Van Puijenbroek, E. N. P. (2007). "Clindamycin and taste disorders". British Journal of Clinical Pharmacology. 64 (4): 542–545. doi:10.1111/j.1365-2125.2007.02908.x. PMC 2048568. PMID 17635503.
- ↑ Starr J (2005). "Clostridium difficile associated diarrhoea: diagnosis and treatment". BMJ. 331 (7515): 498–501. doi:10.1136/bmj.331.7515.498. PMC 1199032. PMID 16141157. Archived from the original on 9 March 2008.
- ↑ Kelly, Ciaran P.; Pothoulakis, Charalabos; LaMont, J. Thomas (27 January 1994). "Clostridium difficile Colitis". New England Journal of Medicine. 330 (4): 257–262. doi:10.1056/NEJM199401273300406. ISSN 0028-4793. PMID 8043060.
- ↑ Lell, Bertrand; Kremsner, Peter G. (1 August 2002). "Clindamycin as an Antimalarial Drug: Review of Clinical Trials". Antimicrobial Agents and Chemotherapy. 46 (8): 2315–2320. doi:10.1128/AAC.46.8.2315-2320.2002. ISSN 0066-4804. PMC 127356. PMID 12121898.
- ↑ American Academy of Pediatrics Committee on Drugs (September 2001). "Transfer of drugs and other chemicals into human milk". Pediatrics. 108 (3): 776–89. doi:10.1542/peds.108.3.776. PMID 11533352.
- ↑ Breastfeeding and maternal medication : recommendations for drugs in the Eleventh WHO Model List of Essential Drugs (Report). World Health Organization. 2002. hdl:10665/62435.
- ↑ Hale, Thomas Wright (2017). Medications & mothers' milk. Rowe, Hilary E. (Seventeenth ed.). New York, NY: Springer. ISBN 9780826128584. OCLC 959873270.
- ↑ Mitrano, Jennifer A; Spooner, Linda M; Belliveau, Paul (1 September 2009). "Excretion of Antimicrobials Used to Treat Methicillin-ResistantStaphylococcus aureusInfections During Lactation: Safety in Breastfeeding Infants". Pharmacotherapy. 29 (9): 1103–1109. doi:10.1592/phco.29.9.1103. ISSN 1875-9114. PMID 19698015.
- ↑ "Clindamycin". Drugs and Lactation Database (LactMed). National Library of Medicine (US). 2006. PMID 30000267. Bookshelf ID: NBK501208. Archived from the original on 5 December 2020. Retrieved 13 November 2019.
- ↑ Fogdall RP, Miller RD (1974). "Prolongation of a pancuronium-induced neuromuscular blockade by clindamycin". Anesthesiology. 41 (4): 407–8. doi:10.1097/00000542-197410000-00023. PMID 4415332.
- ↑ al Ahdal O, Bevan DR (1995). "Clindamycin-induced neuromuscular blockade". Can J Anaesth. 42 (7): 614–7. doi:10.1007/BF03011880. PMID 7553999.
- ↑ Sloan PA, Rasul M (2002). "Prolongation of rapacuronium neuromuscular blockade by clindamycin and magnesium" (PDF). Anesth Analg. 94 (1): 123–4, table of contents. doi:10.1097/00000539-200201000-00023. PMID 11772813. Archived (PDF) from the original on 25 February 2020. Retrieved 4 April 2011.
- ↑ 55.0 55.1 55.2 55.3 55.4 55.5 55.6 Spížek, J.; Řezanka, T. (1 May 2004). "Lincomycin, clindamycin and their applications". Applied Microbiology and Biotechnology. 64 (4): 455–464. doi:10.1007/s00253-003-1545-7. ISSN 1432-0614. PMID 14762701.
- ↑ Clindamycin University of Michigan. Retrieved July 31, 2009
- ↑ Wilson, Daniel N. (2014). "Ribosome-targeting antibiotics and mechanisms of bacterial resistance". Nature Reviews Microbiology. 12 (1): 35–48. doi:10.1038/nrmicro3155. PMID 24336183.
- ↑ Beauduy CE, Winston LG. Tetracyclines, Macrolides, Clindamycin, Chloramphenicol, Streptogramins, & Oxazolidinones. In: Katzung BG. eds. Basic & Clinical Pharmacology, 14e New York, NY: McGraw-Hill; .
- ↑ Dunkle, Jack A.; Xiong, Liqun; Mankin, Alexander S.; Cate, Jamie H. D. (5 October 2010). "Structures of the Escherichia coli ribosome with antibiotics bound near the peptidyl transferase center explain spectra of drug action". Proceedings of the National Academy of Sciences. 107 (40): 17152–17157. doi:10.1073/pnas.1007988107. ISSN 0027-8424. PMC 2951456. PMID 20876128.
- ↑ Schlünzen, Frank; Zarivach, Raz; Harms, Jörg; Bashan, Anat; Tocilj, Ante; Albrecht, Renate; Yonath, Ada; Franceschi, François (2001). "Structural basis for the interaction of antibiotics with the peptidyl transferase centre in eubacteria". Nature. 413 (6858): 814–821. doi:10.1038/35101544. PMID 11677599.
- ↑ Tu, Daqi; Blaha, Gregor; Moore, Peter B.; Steitz, Thomas A. (2005). "Structures of MLSBK Antibiotics Bound to Mutated Large Ribosomal Subunits Provide a Structural Explanation for Resistance". Cell. 121 (2): 257–270. doi:10.1016/j.cell.2005.02.005. PMID 15851032.
- ↑ Matzov, Donna; Eyal, Zohar; Benhamou, Raphael I.; Shalev-Benami, Moran; Halfon, Yehuda; Krupkin, Miri; Zimmerman, Ella; Rozenberg, Haim; Bashan, Anat (2017). "Structural insights of lincosamides targeting the ribosome of Staphylococcus aureus". Nucleic Acids Research. 45 (17): 10284–10292. doi:10.1093/nar/gkx658. PMC 5622323. PMID 28973455.
- ↑ 63.0 63.1 "Clindamycin Phosphate Topical Solution". RxList. Archived from the original on 2 February 2017. Retrieved 27 January 2017.
- ↑ Birkenmeyer, R. D.; Kagan, F. (1970). "Lincomycin. XI. Synthesis and structure of clindamycin, a potent antibacterial agent". Journal of Medicinal Chemistry. 13 (4): 616–619. doi:10.1021/jm00298a007. PMID 4916317.
- ↑ Meyers BR, Kaplan K, Weinstein L (1969). "Microbiological and Pharmacological Behavior of 7-Chlorolincomycin". Appl Microbiol. 17 (5): 653–7. PMC 377774. PMID 4389137.
- ↑ Magerlein, B. J.; Birkenmeyer, R. D.; Kagan, F. (1966). "Chemical modification of lincomycin". Antimicrobial Agents and Chemotherapy. 6: 727–736. PMID 5985307.
- ↑ Cunha, Burke A.; Cunha, Burke (2009). Infectious Diseases in Critical Care Medicine. CRC Press. p. 506. ISBN 978-1-4200-9241-7. Archived from the original on 28 August 2021. Retrieved 30 March 2020.
- ↑ "Clindamycin". International Drug Price Indicator Guide. Archived from the original on 7 January 2016. Retrieved 6 September 2015.
- ↑ Cunliffe WJ, Holland KT, Bojar R, Levy SF (2002). "A randomized, double-blind comparison of a clindamycin phosphate/benzoyl peroxide gel formulation and a matching clindamycin gel with respect to microbiologic activity and clinical efficacy in the topical treatment of acne vulgaris". Clin Ther. 24 (7): 1117–33. doi:10.1016/S0149-2918(02)80023-6. PMID 12182256.
- ↑ Waknine, Yael (1 December 2006). "FDA Approvals: Ziana, Kadian, Polyphenon E". Medscape Medical News. Archived from the original on 6 February 2011. Retrieved 1 December 2007.
- ↑ "Generic Cleocin Vaginal Availability". Drugs.com. Archived from the original on 13 October 2019. Retrieved 13 October 2019.
- ↑ (February 8, 2005) "Osteomyelitis" Archived 2008-01-07 at the Wayback Machine, in Kahn, Cynthia M., Line, Scott, Aiello, Susan E. (ed.): The Merck Veterinary Manual, 9th ed., John Wiley & Sons. ISBN 0-911910-50-6. Retrieved 14 December 2007.
- ↑ (February 8, 2005) "Toxoplasmosis: Introduction" Archived 2007-12-20 at the Wayback Machine, in Kahn, Cynthia M., Line, Scott, Aiello, Susan E. (ed.): The Merck Veterinary Manual, 9th ed., John Wiley & Sons. ISBN 0-911910-50-6. Retrieved 14 December 2007.
External links
| External sites: |
|
|---|---|
| Identifiers: |